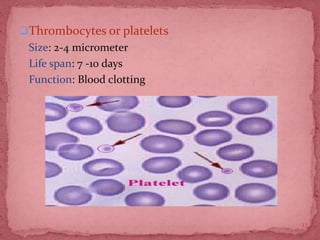
Thrombocytes or platelets
Size: 2-4 micrometer
Life span: 7 -10 days
Function: Blood clotting
13

The document provides a comprehensive overview of hematology, detailing its definition, purpose, and the significance of hematological tests and blood analysis. It covers topics such as blood composition, collection methods, laboratory equipment, and various hematological diseases and their tests. Additionally, safety measures and laboratory protocols are highlighted to ensure protection against potential hazards in the clinical hematology setting.